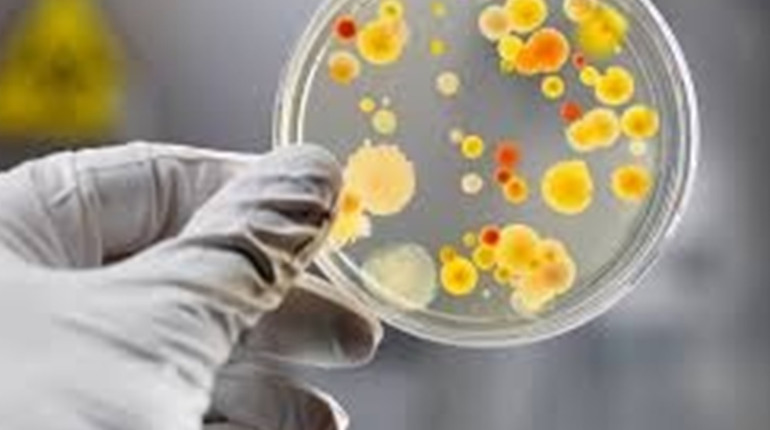

Восени збільшується ризик підхопити низку інфекційних хвороб, які можуть переносити пацюки та миші. Лептоспіроз – найнебезпечніша та найпоширеніша з них. Чому небезпека зростає саме зараз, до чого тут масове переселення гризунів і як себе вберегти – зʼясовував Центр громадського моніторингу та контролю.
Зерно та риболовля? Небезпека поруч!
Станом на 15 серпня на Черкащині було зареєстровано п’ять випадків лептоспірозу. Серед хворих – 54-річний чоловік.
– Ймовірне місце зараження – приміщення для зберігання зерна, де були виявлені сліди життєдіяльності гризунів. Чоловік мав пошкодження шкіри на руках та контактував із зерном голими руками, – про це розповів Суспільному головний державний санітарний лікар області Володимир Папач.
Фахівці 7 вересня повідомили, що на Львівщині лептоспіроз підхопили двоє літніх людей – жінка та чоловік. Останній, після лікування вдома, потрапив до лікарні у важкому стані. Серед симптомів: підвищена температура, біль у м'язах, почервоніння очей та жовтяниця. Ймовірний шлях зараження – контактний: чоловік займався рибальством на річці Західний Буг.
Загалом, за сім місяців 2025 року в країні зафіксовано 89 випадків лептоспірозу. Це небезпечна інфекційна хвороба. Її збудником є бактерії роду Leptospira. Експерти зазначають, що переносниками інфекції можуть бути бабаки, собаки, велика рогата худоба, свині та коні. А в Україні її найчастіше поширюють сірі щури та польові миші.
Осінь і масове переселення ближче до людей
Гризуни, особливо миші та пацюки, масово переселяються ближче до людей наприкінці літа та восени. Хвостасті шукають місця для зимівлі з теплом та їжею. «Непрохані гості» селяться у будинках, підвалах, зерносховищах та складах. Там вони живуть до весни.
У Центрі громадського здоров’я України зазначають, що це створює додатковий ризик поширення особливо небезпечних інфекційних хвороб. Наприклад, лептоспірозу, лістеріозу, туляремії та інших, які передаються через харчові продукти й воду, забруднені сечею і фекаліями інфікованих гризунів, а також через їхні укуси.
Лептоспіроз є найнебезпечнішим і найпоширенішим з них. Сезонний пік захворюваності на цю недугу припадає на серпень, вересень та жовтень.

Від гарячки до ураження печінки
Лептоспіроз передається через укуси гризунів, пошкоджену шкіру або слизові оболонки. Інфікування також можливе під час вживання їжі чи води, забруднених сечею заражених тварин, а також під час купання, риболовлі або догляду за хворими тваринами.
У ЦГЗ інформують, що людина може захворіти у період від двох днів до чотирьох тижнів після зараження. Симптоми варіюються від легких (головний біль, гарячка, біль у м’язах, почервоніння очей, діарея, висипання) до серйозних (ураження нирок, печінки, менінгіт). Хвороба може призвести до смерті. У 2024 році від недуги померли 63 людини, а у 2023-му – 52.
За словами експертів, дуже часто лептоспіроз можна сплутати із гепатитом, оскільки жовтіє обличчя. Якщо людина бачить зміни у своєму здоров’ї, не треба займатись самолікуванням.
– Особливо важливо дуже швидко звернутися до лікаря. Адже при цій інфекції важливе саме раннє звернення. Якщо вже пройшло кілька днів – можуть бути дуже погані прогнози. Летальність при цій інфекції сягає 14 відсотків. Тобто 14 людей із 100 хворих можуть померти, – розповів в ефірі Громадського радіо генеральний директор Центру громадського здоровʼя, доктор медичних наук Михайло Росада.
Як вберегтись?
Щоб захиститись від хвороб, які переносять гризуни, варто підтримувати чистоту в домі та у дворі. А ще – дотримуватись гігієни, зберігати продукти в закритих контейнерах, пити кип’ячену або бутильовану воду, добре термічно обробляти їжу.
Не купатись у стоячих водоймах. Окрім цього, варто щороку вакцинувати собак і худобу проти лептоспірозу.